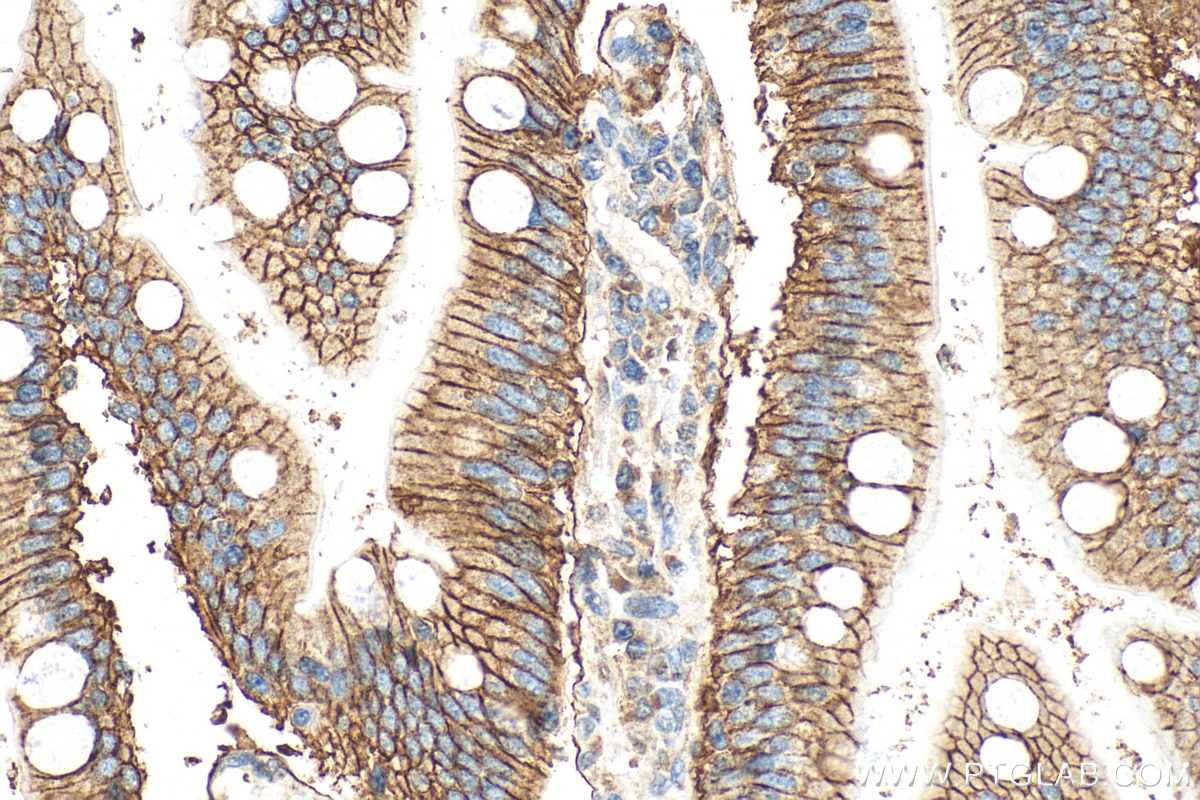
Immunohistochemistry (IHC) staining of human small intestine tissue using GLUT2 Polyclonal antibody (20436-1-AP)
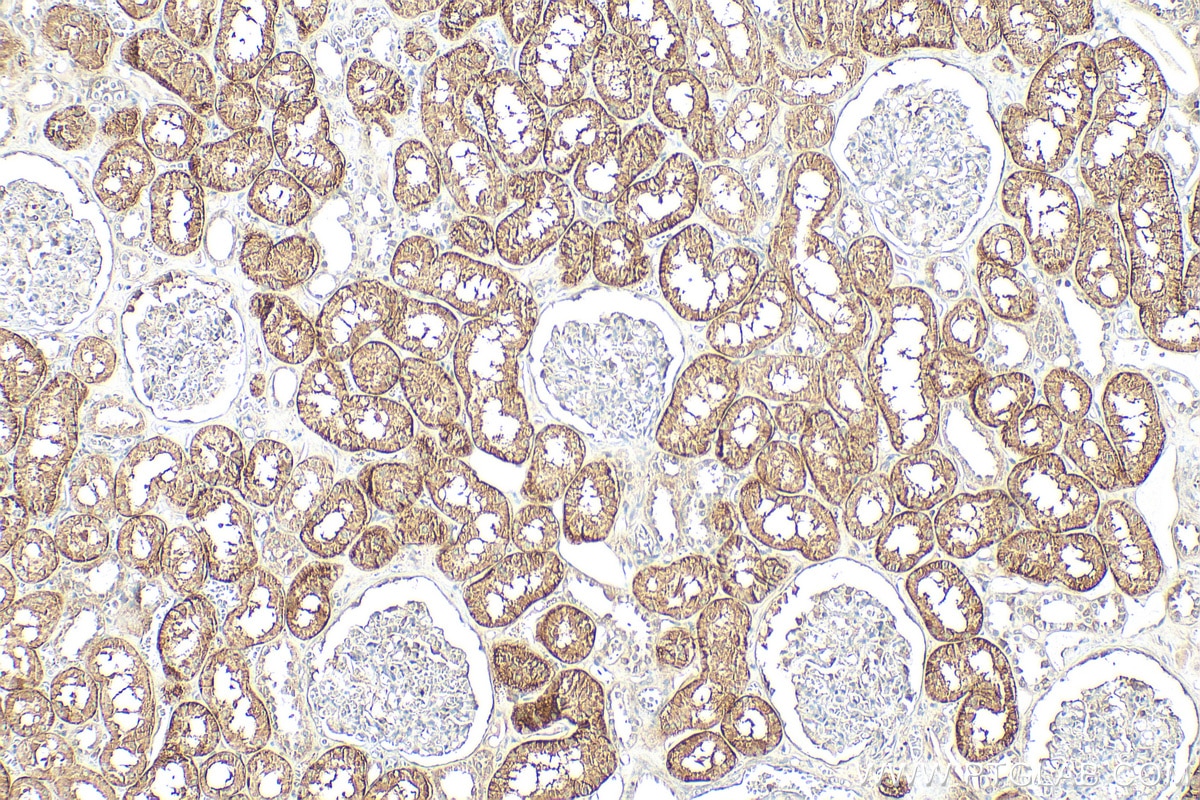
Immunohistochemistry (IHC) staining of human kidney tissue using GLUT2 Polyclonal antibody (20436-1-AP)

Validation Data Gallery
Tested Applications
| Positive WB detected in | Caco-2 cells, mouse kidney tissue, HEK 293 cells, HepG2 cells, NIH/3T3 cells, mouse liver tissue, rat liver tissue |
| Positive IP detected in | mouse kidney tissue |
| Positive IHC detected in | mouse pancreas tissue, human kidney tissue, human small intestine tissue Note: suggested antigen retrieval with TE buffer pH 9.0; (*) Alternatively, antigen retrieval may be performed with citrate buffer pH 6.0 |
Recommended dilution
| Application | Dilution |
|---|---|
| Western Blot (WB) | WB : 1:500-1:3000 |
| Immunoprecipitation (IP) | IP : 0.5-4.0 ug for 1.0-3.0 mg of total protein lysate |
| Immunohistochemistry (IHC) | IHC : 1:500-1:2000 |
| It is recommended that this reagent should be titrated in each testing system to obtain optimal results. | |
| Sample-dependent, Check data in validation data gallery. | |
Published Applications
| WB | See 71 publications below |
| IHC | See 15 publications below |
| IF | See 13 publications below |
Product Information
20436-1-AP targets GLUT2 in WB, IHC, IF, IP, ELISA applications and shows reactivity with human, mouse, rat samples.
| Tested Reactivity | human, mouse, rat |
| Cited Reactivity | human, mouse, rat, pig, sheep, lasiopodomys brandtii |
| Host / Isotype | Rabbit / IgG |
| Class | Polyclonal |
| Type | Antibody |
| Immunogen |
CatNo: Ag14204 Product name: Recombinant human SLC2A2 protein Source: e coli.-derived, PGEX-4T Tag: GST Domain: 69-128 aa of BC060041 Sequence: SPRYLYIKLDEEVKAKQSLKRLRGYDDVTKDINEMRKEREEASSEQKVSIIQLFTNSSYR 相同性解析による交差性が予測される生物種 |
| Full Name | solute carrier family 2 (facilitated glucose transporter), member 2 |
| Calculated molecular weight | 57 kDa |
| Observed molecular weight | 60-70 kDa, 38-45 kDa |
| GenBank accession number | BC060041 |
| Gene Symbol | GLUT2 |
| Gene ID (NCBI) | 6514 |
| RRID | AB_2750600 |
| Conjugate | Unconjugated |
| Form | |
| Form | Liquid |
| Purification Method | Antigen affinity purification |
| UNIPROT ID | P11168 |
| Storage Buffer | PBS with 0.02% sodium azide and 50% glycerol{{ptg:BufferTemp}}7.3 |
| Storage Conditions | Store at -20°C. Stable for one year after shipment. Aliquoting is unnecessary for -20oC storage. |
Background Information
Glucose transporter 2 (GLUT2), also known as solute carrier family 2, facilitated glucose transporter member 2 (SLC2A2), is a transporter protein regulating glucose transport across cell membranes in an insulin-independent manner.
What is the molecular weight of GLUT2? Is GLUT2 post-translationally modified?
GLUT2 can be N-glycosylated. The molecular weight of mature glycosylated GLUT2 transporter is between 55 and 65 kDa, but a minor 38-kDa form is often detected in hepatocytes that may represent a non-glycosylated or proteolytic product (PMID: 12101013).
What is the subcellular localization of GLUT2?
Glucose transporters, including GLUT2, are multiple-pass integral membrane proteins. GLUT2 is present at the plasma membrane but has also been reported to be present at intracellular membranes, including the endoplasmic reticulum (PMID: 12101013).
What molecules can be transported by GLUT2?
Although the main substrate of GLUT2 transport is glucose, it can also transport galactose, mannose, and fructose.
What is the tissue expression pattern of GLUT2?
GLUT2 is expressed in many cell types. High expression of GLUT2 is observed in hepatocytes, where GLUT2 mediates glucose uptake and release regulating glucose levels in blood, in intestinal cells, where it regulates glucose transport at the basolateral membrane and to a lesser extent from the apical membrane, and in the kidney proximal tubule, where it is involved in glucose reabsorption and is present at the basolateral membrane.
Protocols
| Product Specific Protocols | |
|---|---|
| IHC protocol for GLUT2 antibody 20436-1-AP | Download protocol |
| IP protocol for GLUT2 antibody 20436-1-AP | Download protocol |
| WB protocol for GLUT2 antibody 20436-1-AP | Download protocol |
| Standard Protocols | |
|---|---|
| Click here to view our Standard Protocols |
Publications
| Species | Application | Title |
|---|---|---|
Clin Transl Med USP7 promotes non-small-cell lung cancer cell glycolysis and survival by stabilizing and activating c-Abl | ||
Cell Mol Gastroenterol Hepatol Patient-Derived Mutant Forms of NFE2L2/NRF2 Drive Aggressive Murine Hepatoblastomas. | ||
Mol Metab T1R2 receptor-mediated glucose sensing in the upper intestine potentiates glucose absorption through activation of local regulatory pathways. | ||
Metabolism Rheb1 promotes glucose-stimulated insulin secretion in human and mouse β-cells by upregulating GLUT expression. |